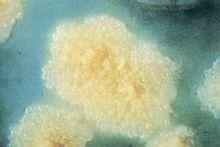
結核桿菌菌落-羅氏培養基

研究歷史
![MTB[結核分枝桿菌的縮寫]](/img/5/a92/wZwpmLzIjN1EjN0EDN2EzM1UTM1QDN5MjM5ADMwAjMwUzLxQzL4QzLt92YucmbvRWdo5Cd0FmLyE2LvoDc0RHa.jpg) MTB[結核分枝桿菌的縮寫]
MTB[結核分枝桿菌的縮寫] 結核桿菌抗酸染色陽性(紅色)
結核桿菌抗酸染色陽性(紅色)結核分枝桿菌(M. tuberculosis)簡稱為結核桿菌(tubercle bacilli)。早在1882年,德國細菌學家柯赫(Robert Koch,1843-1910)就已證明結核分枝桿菌是結核病的病原菌。本菌可侵犯全身各組織器官,但以肺部感染最多見。隨著抗結核藥物的不斷發展和衛生生活狀況的改善,結核的發病率和死亡率曾一度大幅下降。20世紀80年代後,由於愛滋病和結核分枝桿菌耐藥菌株的出現、免疫抑制劑的套用、吸毒、貧困及人口流動等因素,全球範圍內結核病的疫情驟然惡化。據WHO統計,全世界約每3個人中就有1個人感染了結核分枝桿菌,在某些開發中國家成人中結核分枝桿菌攜帶率高達80%,其中約5%~10%攜帶者可發展為活動性結核病。近二十年由於愛滋病的流行,感染了HIV的結核分枝桿菌攜帶者,由於病毒破壞了機體的免疫功能,發展為活動性結核病的可能性比未感染HIV者高30~50倍,且結核的病程發展更快。此外,在HIV感染的發展進程中,結核是最早發生的一種機會性感染,結核病加重了HIV感染者或愛滋病人的疾病負擔,使其更易死亡。21世紀以來全球每年約出現8百萬結核新病例,並導致約3百萬人死亡。中國每年死於結核病的人約25萬之多,是各類傳染病死亡人數總和的兩倍多。因此,結核病又成為了威脅人類健康的全球性衛生問題,並成為某些開發中國家和地區,特別是愛滋病高發區人群的首要死因。
生物學性狀
形態與染色
結核分枝桿菌為細長略帶彎曲的桿菌,大小1~4X0.4μm。牛分枝桿菌則比較粗短。分枝桿菌屬的細菌細胞壁脂質含量較高,約占乾重的60%,特別是有大量分枝菌酸(mycolic acid)包圍在肽聚糖層的外面,可影響染料的穿入。分枝桿菌一般用齊尼(Ziehl- Neelsen)抗酸染色法,以5% 石炭酸復紅加溫染色後可以染上,但用3%鹽酸乙醇不易脫色。若再加用美藍復染,則分枝桿菌呈紅色,而其他細菌和背景中的物質為藍色。本菌無芽孢、無鞭毛。
 結核分枝桿菌 抗酸染色 ×1000
結核分枝桿菌 抗酸染色 ×1000近年發現結核分枝桿菌在細胞壁外尚有一層莢膜。一般因製片時遭受破壞而不易看到。若在製備電鏡標本固定前用明膠處理,可防止莢膜脫水收縮。在電鏡下可看到菌體外有一層較厚的透明區,即莢膜,莢膜對結核分枝桿菌有一定的保護作用。
結核分枝桿菌在體內外經青黴素、環絲氨酸或溶菌酶誘導可影響細胞壁中肽聚糖的合成,異煙肼影響分枝菌酸的合成,巨噬細胞吞噬結核分枝桿菌後溶菌酶的作用可破壞肽聚糖,均可導致其變為L型,呈顆粒狀或絲狀。異煙肼影響分枝菌酸的合成,可變為抗酸染色陰性。這種形態多形染色多變在肺內外結核感染標本中常能見到。臨床結核性冷膿瘍和痰標本中甚至還可見有非抗酸性革蘭陽性顆粒,過去稱為Much顆粒。該顆粒在體內或細胞培養中能返回為抗酸性桿菌,故亦為L型。
培養特性
專性需氧。最適溫度為37℃,低於30℃不生長。結核分枝桿菌細胞壁的脂質含量較高,影響營養物質的吸收,故生長緩慢。在一般培養基中每分裂1代需時18~24小時,營養豐富時只需5小時。
結核桿菌菌落-羅氏培養基
結核桿菌菌落-羅氏培養基初次分離需要營養豐富的培養基。常用的有羅氏(Lowenstein-Jensen)固體培養基,內含蛋黃、甘油、馬鈴薯、無機鹽和孔雀綠等。孔雀綠可抑制雜菌生長,便於分離和長期培養。蛋黃含脂質生長因子,能刺激生長。根據接種菌多少,一般2~4周可見菌落生長。菌落呈顆粒、結節或花菜狀,乳白色或米黃色,不透明。在液體培養基中可能由於接觸營養面大,細菌生長較為迅速。一般1~2周即可生長。臨床標本檢查液體培養比固體培養的陽性率高數倍。
生化反應
![MTB[結核分枝桿菌的縮寫]](/img/e/56a/wZwpmL4QjMwQjNwkzM2EzM1UTM1QDN5MjM5ADMwAjMwUzL5MzL3MzLt92YucmbvRWdo5Cd0FmLxE2LvoDc0RHa.jpg) MTB[結核分枝桿菌的縮寫]
MTB[結核分枝桿菌的縮寫]結核分枝桿菌不發酵糖類。與牛分枝桿菌的區別在於結核分枝桿菌可合成煙酸和還原硝酸鹽,而牛分枝桿菌不能。熱觸酶試驗對區別結核分枝桿菌與非結核分枝桿菌有重要意義。結核分枝桿菌大多數觸酶試驗陽性,而熱觸酶試驗陰性; 非結核分枝桿菌則大多數兩種試驗均陽性。熱觸酶試驗檢查方法是將濃的細菌懸液置68℃水浴加溫20分鐘,然後再加H2O2。觀察是否產生氣泡,有氣泡者為陽性。
抵抗力
 掃描電子顯微鏡下的結核桿菌
掃描電子顯微鏡下的結核桿菌結核分枝桿菌細胞壁中含有脂質,故對乙醇敏感,在70%乙醇中2min死亡。此外,脂質可防止菌體水分丟失,故對乾燥的抵抗力特彆強。粘附在塵埃上保持傳染性8~10d,在乾燥痰內可存活6~8個月。結核分枝桿菌對濕熱敏感,在液體中加熱62~63℃ 15分鐘或煮沸即被殺死。結核分枝桿菌對紫外線敏感。直接日光照射數小時可被殺死,可用於結核患者衣服、書籍等的消毒。
結核分枝桿菌的抵抗力與環境中有機物的存在有密切關係,如痰液可增強結核分枝桿菌的抵抗力。因大多數消毒劑可使痰中的蛋白質凝固,包在細菌周圍,使細菌不易被殺死。5%石炭酸在無痰時30min可殺死結核分枝桿菌,有痰時需要24h;5% 來蘇兒無痰時5min殺死結核分枝桿菌,有痰時需要1~2h。
結核分枝桿菌對酸(3% HCl或6% H2SO4)或鹼(4% NaOH)有抵抗力,15分鐘不受影響。可在分離培養時用於處理有雜菌污染的標本和消化標本中的粘稠物質。結核分枝桿菌對1:13 000孔雀綠有抵抗力,加在培養基中可抑制雜菌生長。結核分枝桿菌對鏈黴素、異煙肼、利福平、環絲氨酸、乙胺丁醇、卡那黴素、對氨基水楊酸等敏感,但長期用藥容易出現耐藥性,而吡嗪醯胺的耐藥性<5%。
變異性
![MTB[結核分枝桿菌的縮寫]](/img/9/e25/wZwpmL1gTMycjM1MzM2EzM1UTM1QDN5MjM5ADMwAjMwUzLzMzL1AzLt92YucmbvRWdo5Cd0FmLzE2LvoDc0RHa.jpg) MTB[結核分枝桿菌的縮寫]
MTB[結核分枝桿菌的縮寫]結核分枝桿菌可發生形態、菌落、毒力、免疫原性和耐藥性等變異。卡介苗(BCG)就是Calmette和Guerin (1908)將牛結核分枝桿菌在含甘油、膽汁、馬鈴薯的培養基中經13年230次傳代而獲得的減毒活疫苗株,現廣泛用於預防接種。
強韌性
因結核桿菌體內含有大量類脂質,占結核菌乾重的40%,細胞壁內含量最多,因其富脂外壁的疏水性之故,一般的消毒劑難以滲入,對外界條件有異常大的抵抗力,使通常的滅菌方法易失敗,15%硫酸或15%氫氧化鈉溶液處理30分鐘,可殺死一般的病原菌,但不能殺死結核桿菌。在陰暗潮濕的地方可生存數月,在陽光暴曬下能生存數小時,在-7℃以下可生存4~5年。但在沸水中(100℃)數分鐘可死亡,因此,煮沸消毒是最有效最經濟的方法。醇脂性溶劑———酒精能滲入其酯層而發揮奇效,用75%酒精2分鐘便可將它殺死。
條件性
![MTB[結核分枝桿菌的縮寫]](/img/3/9f4/wZwpmLwAjN0YzM5IDN2EzM1UTM1QDN5MjM5ADMwAjMwUzLyQzL0QzLt92YucmbvRWdo5Cd0FmLzE2LvoDc0RHa.jpg) MTB[結核分枝桿菌的縮寫]
MTB[結核分枝桿菌的縮寫]結核菌在含氧40%~50%並有5%~10%CO2和溫度為36℃±5℃,合適PH值為6.8~7.2的條件下生長旺盛,並且在一般的培養基上結核桿菌是不生長的,它必須在含有血清、卵黃、馬鈴薯、甘油以及某些無機鹽類的特殊培養基上才能生長。所以結核菌最易侵犯氧氣充足、血流、營養豐富的肺臟以及骨骼的兩端。結核桿菌無論在什麼環境中的存在,都已顯示出,它是細菌家族中最優秀的菌種之一。
懶惰性
結核桿菌生長緩慢,無運動能力,性情懶惰,其最快分裂增殖速度為18小時一代,而大多數細菌都是幾分鐘或幾十分鐘便繁殖一代,如大腸桿菌約需20分鐘便可繁殖一代,10小時後,一個大腸桿菌繁殖10億個以上,可是一個結核桿菌18個小時才繁殖2個。可別小看或輕視結核桿菌帶有這種欺騙性形似疲憊的懶惰行為,大量科學家在實驗室或醫務人員在臨床與它進行長期鬥爭的實踐一再證明,我們與它鬥爭的手段還沒有提高到一個高水平上來。
易發生耐藥性
![MTB[結核分枝桿菌的縮寫]](/img/4/5f0/wZwpmLwATN5MjM4MDN2EzM1UTM1QDN5MjM5ADMwAjMwUzLzQzL0YzLt92YucmbvRWdo5Cd0FmLwE2LvoDc0RHa.jpg) MTB[結核分枝桿菌的縮寫]
MTB[結核分枝桿菌的縮寫]在固體培養基中對常用的含異煙肼1mg、鏈黴素10mg、利福平50mg能生長的結核分枝桿菌為耐藥菌。耐藥菌株毒力有所減弱。異煙肼可影響細胞壁中分枝菌酸的合成,誘導結核分枝桿菌成為L型,此可能是耐異煙肼的一種原因。藥物敏感試驗表明對異煙肼耐藥,而對利福平和鏈黴素大多仍敏感。故目前治療多主張異煙肼和利福平或吡嗪醯胺聯合用藥,以減少耐藥性的產生,增強療效。臨床上耐異煙肼菌株致病性也有所減弱。實驗證明豚鼠感染結核分枝桿菌常於6周內死亡,且肝內見有粟粒性病灶; 而感染L型後往往要百餘天才死亡,病灶缺乏典型結核結節病變。但L型有回覆的特性,未經徹底治療可導致復發。
近年來世界各地結核分枝桿菌的多耐菌株逐漸增多,甚至引起暴發流行。結核分枝桿菌的耐藥可由自發突變產生(原發性耐藥)或由用藥不當經突變選擇產生(繼發性耐藥)。但多耐的產生主要可能由於後者。耐藥基因在染色體上,對不同藥物的耐藥基因不相連線,所以聯合用藥治療有效。對異煙肼耐藥與katG基因丟失有關。易感株有該基因,耐藥株無。利福平主要作用於RNA多聚酶。編碼該酶的基因(rpoB)突變則引起對利福平耐藥。1999年國內報導7株耐利福平株全部rpoB基因發生突變。敏感株則否。
致病性
結核分枝桿菌不產生內、外毒素。其致病性可能與細菌在組織細胞內大量繁殖引起的炎症,菌體成分和代謝物質的毒性以及機體對菌體成分產生的免疫損傷有關。
致病物質
與莢膜、脂質和蛋白質有關。
1.莢膜 莢膜的主要成分為多糖,部分脂質和蛋白質。其對結核分枝桿菌的作用有:
①莢膜能與吞噬細胞表面的補體受體3(CR3)結合,有助於結核分枝桿菌在宿主細胞上的粘附與入侵;
②莢膜中有多種酶可降解宿主組織中的大分子物質,供入侵的結核分枝桿菌繁殖所需的營養;
③莢膜能防止宿主的有害物質進入結核分枝桿菌,甚至如小分子NaOH也不易進入。故結核標本用4% NaOH消化時,一般細菌很快殺死,但結核分枝桿菌可耐受數十分鐘。結核分枝桿菌入侵後莢膜還可抑制吞噬體與溶酶體的融合。
2.脂質 據實驗研究細菌毒力可能與其所含複雜的脂質成分有關,特別是糖脂更為重要。
 結核分枝桿菌
結核分枝桿菌①索狀因子 :是分枝菌酸和海藻糖結合的一種糖脂。能使細菌在液體培養基中呈蜿蜒索狀排列。此因子與結 核分枝桿菌毒力密切相關。它能破壞細胞線粒體膜,影響細胞呼吸,抑制白細胞遊走和引起慢性肉芽腫。若將其從細菌中提出,則細菌喪失毒力。
②磷脂:能促使單核細胞增生,並使炎症灶中的巨噬細胞轉變為類上皮細胞,從而形成結核結節。
③硫酸腦苷脂(sulfatide):可抑制吞噬細胞中吞噬體與溶酶體的結合,使結核分枝桿菌能在吞噬細胞中長期存活。
④蠟質D:是一種肽糖脂和分枝菌酸的複合物,可從有毒株或卡介苗中用甲醇提出,具有佐劑作用,可激發機體產生遲髮型超敏反應。
3.蛋白質 有抗原性,和蠟質D結合後能使機體發生超敏反應,引起組織壞死和全身中毒症狀,並在形成結核結節中發揮一定作用。
所致疾病
![MTB[結核分枝桿菌的縮寫]](/img/8/664/wZwpmLxUDM5IjNwgzM2EzM1UTM1QDN5MjM5ADMwAjMwUzL4MzLxIzLt92YucmbvRWdo5Cd0FmLwE2LvoDc0RHa.jpg) MTB[結核分枝桿菌的縮寫]
MTB[結核分枝桿菌的縮寫]結核分枝桿菌可通過呼吸道、消化道或皮膚損傷侵入易感機體,引起多種組織器官的結核病,其中以通過呼吸道引起肺結核為最多。因腸道中有大量正常菌群寄居,結核分枝桿菌必須通過競爭才能生存並和易感細胞粘附。肺泡中無正常菌群,結核分枝桿菌可通過飛沫微滴或含菌塵埃的吸入,故肺結核較為多見。1.肺部感染 由於感染菌的毒力、數量、機體的免疫狀態不同,肺結核可有以下兩類表現。
⑴原發感染:多發生於兒童。肺泡中有大量巨噬細胞,少數活的結核分枝桿菌進入肺泡即被巨噬細胞吞噬。由於該菌有大量脂質,可抵抗溶菌酶而繼續繁殖,使巨噬細胞遭受破壞,釋放出的大量菌在肺泡內引起炎症,稱為原發灶。初次感染的機體因缺乏特異性免疫,結核分枝桿菌常經淋巴管到達肺門淋巴結,引起肺門淋巴結腫大,稱原發綜合徵。此時,可有少量結核分枝桿菌進入血液,向全身擴散,但不一定有明顯症狀(稱隱性菌血症);與此同時灶內巨噬細胞將特異性抗原遞呈給周圍淋巴細胞。感染3~6周,機體產生特異性細胞免疫,同時也出現超敏反應。病灶中結核分枝桿菌細胞壁磷脂,一方面刺激巨噬細胞轉化為上皮樣細胞,後者相互融合或經核分裂形成多核巨細胞(即朗罕巨細胞),另一方面抑制蛋白酶對組織的溶解,使病灶組織溶解不完全,產生乾酪樣壞死,周圍包著上皮樣細胞,外有淋巴細胞、巨噬細胞和成纖維細胞,形成結核結節(即結核肉芽腫)是結核的典型病理特徵。感染後約5% 可發展為活動性肺結核,其中少數患者因免疫低下,可經血和淋巴系統,播散至骨、關節、腎、腦膜及其他部位引起相應的結核病。90% 以上的原發感染形成纖維化或鈣化,不治而愈,但病灶內常仍有一定量的結核分枝桿菌長期潛伏,不但能刺激機體產生免疫也可成為日後內源性感染的淵源。
⑵原發後感染:病灶亦以肺部為多見。病菌可以是外來的(外源性感染)或原來潛伏在病灶內(內源性感染)。由於機體已有特異性細胞免疫,因此原發後感染的特點是病灶多局限,一般不累及鄰近的淋巴結,被纖維素包圍的乾酪樣壞死灶可鈣化而痊癒。若干酪樣結節破潰,排入鄰近支氣管,則可形成空洞並釋放大量結核分枝桿菌至痰中。
1990國外報導各種類型肺結核,40%痰標本檢出L型。近年來有人注意到病灶中見有形態不典型的抗酸菌卻未見典型結核結節,稱之為“無反應性結核”。用結核分枝桿菌L型感染實驗動物,也見有同樣情況。這是由於結核分枝桿菌L型缺少細胞壁脂質成分,不能刺激結節形成,而僅有淋巴結腫大和乾酪樣壞死。單從病理變化判斷,常被誤認為慢性淋巴結炎。有人對155例曾診斷為慢性淋巴結炎蠟塊標本作回顧性研究,用卡介苗抗體作免疫酶染色,68.9% 陽性,抗酸染色60%為抗酸顆粒。說明病例中很大一部分與結核分枝桿菌L型有關。臨床上對此應予注意,以防漏診與誤診。
2.肺外感染 部分患者結核分枝桿菌可進入血液循環引起肺內、外播散,如腦、腎結核,痰菌被嚥入消化道也可引起腸結核、結核性腹膜炎等。國外有報導332例血標本僅2例培養出結核分枝桿菌,但將此標本注入豚鼠皮下 12% 感染結核。說明結核分枝桿菌在血中播散的大多不是一般細菌型,而是一種不易生長的L型。近年有不少肺外結核的新報導,結核分枝桿菌的檢出率L型多於細菌型:如兒童結核性腦膜炎10例腦脊液培養,9例培養出L型,細菌型僅1例。老年性前列腺肥大排尿困難,術後病理切片抗酸菌L型占61.2%,無1例為典型抗酸桿菌。慢性前列腺炎常規培養陰性者,近1/3檢出抗酸菌L型。不育症男子精液檢查單見抗酸桿菌7%,單見抗酸L型14%,電鏡檢查見L型吸附於精子頭、尾。以結核分枝桿菌L型感染小鼠,73% 睪丸間質炎症中見有抗酸菌L型。
免疫性
免疫機制
結核分枝桿菌是胞內感染菌,其免疫主要是以T細胞為主的細胞免疫。T細胞不能直接和胞內菌作用,必須先與感染細胞反應,導致細胞崩潰,釋放出結核分枝桿菌。機體對結核分枝桿菌雖能產生抗體,但抗體只能與釋出的細菌接觸起輔助作用。結核分枝桿菌侵入呼吸道後,由於肺泡中80%~90% 是巨噬細胞,10% 是淋巴細胞(T細胞占多數);原肺泡中未活化的巨噬細胞抗菌活性弱,不能防止所吞噬的結核分枝桿菌生長,反可將結核分枝桿菌帶到他處。但可遞呈抗原,使周圍T淋巴細胞致敏。致敏淋巴細胞可產生多種淋巴因子,如IL-2、IL-6、INF- γ,他們與TNF-α的共同作用可殺死病灶中的結核分枝桿菌。淋巴因子中INF-γ是主要的,有多種細胞能產生INF- γ,浸潤的先後為NK、γ /δT和CD4+、CD8+α/βT細胞。上述細胞有的可直接殺傷靶細胞,有的產生淋巴因子激活巨噬細胞,使吞噬作用加強引起呼吸暴發,導致活性氧中介物和活性氮中介物的產生而將病菌殺死。機體內的T細胞根據抗原受體(TCR)的不同可分2種:一種由α鏈與β鏈組成,稱α/βT細胞(含CD4或CD8標誌),另一種由? 鏈和δ鏈組成,稱γ /δT細胞(大多無CD4或CD8標誌)。人與小鼠外周血中前者 ?90%,後者<10%。在抗分枝桿菌免疫中這2種T細胞均起到重要作用。在感染早期α/βT細胞尚未升至高峰時,結核分枝桿菌受γ/δT細胞控制。在與結核分枝桿菌接觸後 γ /δT細胞即大量增殖。健康人經分枝桿菌提取物刺激7~10d後,外周淋巴細胞中γ /δT細胞可有所增加,其作用與α/βT細胞同樣可殺傷結核分枝桿菌。近年來證明小鼠感染牛分枝桿菌後γ /δT細胞迅速匯集到炎症區,增殖的主要是V 9δ2T細胞亞群,但人活動性結核時此亞群有所下降。
近年來注意到γ /δT細胞攻擊的主要是分枝桿菌中的一種熱休克蛋白(heat shock protein,HSP)。HSP是一種具有高度保守性的蛋白質,從原核細胞到動植物中均有,其胺基酸順序有50%同源。在正常生物中含量極少,但在感染、發熱、細胞惡變等外界環境條件改變時即大量產生,故HSP又稱應激蛋白(stress protein)。HSP在許多病原菌中均有,其胺基酸序列有共同成分,不同細菌引起的亞臨床感染均可引起一定程度相同的免疫,被認為是非特異性免疫。
結核的免疫屬於感染免疫(infection immunity),又稱有菌免疫,即只有當結核分枝桿菌或其組分存在體內時才有免疫力。一旦體內的結核分枝桿菌或其組分全部消失,免疫也隨之不存在。
超敏反應
隨著機體對結核分枝桿菌產生保護作用的同時,也可以看到有遲髮型超敏反應的產生,二者均為T細胞介導的結果。從郭霍現象(Koch phenomenon)可以看到,將結核分枝桿菌初次注入健康豚鼠皮下,10~14d後局部潰爛不愈,附近淋巴結腫大,細菌擴散至全身,表現為原發感染的特點。若以結核分枝桿菌對以前曾感染過結核的豚鼠進行再感染 ,則於1~2d內局部迅速產生潰爛,易癒合。附近淋巴結不腫大,細菌亦很少擴散,表現為原發後感染的特點。可見再感染時潰瘍淺、易癒合、不擴散,表明機體已有一定免疫力。但再感染時潰瘍發生快,說明在產生免疫的同時有超敏反應的參與。近年來研究表明結核分枝桿菌誘導機體產生免疫和超敏反應的物質不同。超敏反應主要由結核菌素蛋白和蠟質D共同引起,而免疫則由結核分枝桿菌核糖體RNA(rRNA)引起。二種不同抗原成分激活不同的T細胞亞群釋放出不同的淋巴因子所致。
實驗室診斷
結核菌素試驗
結核菌素試驗是套用結核菌素進行皮膚試驗來測定機體對結核分枝桿菌是否能引起超敏反應的一種試驗。
1.結核菌素試劑 以往用舊結核菌素(old tuberculin,OT)。系將結核分枝桿菌接種於甘油肉湯培養基,培養4~8周后加熱濃縮過濾製成。稀釋2 000倍,每0.1ml含5單位。目前都用純蛋白衍化物(purified protein derivative,PPD)。PPD有二種:人結核分枝桿菌製成的PPD-C和卡介苗製成的BCG-PPD。每0.1ml含5單位。
2.試驗方法與意義 常規試驗分別取2種PPD 5個單位注射兩前臂皮內,48~72h後紅腫硬結超過5mm者為陽性,≥15mm為強陽性,對臨床診斷有意義。若PPD-C側紅腫大於BCG-PPD側為感染。反之,BCG-PPD側大於PPD-C側,可能系卡介苗接種所致。
陰性反應表明未感染過結核分枝桿菌,但應考慮以下情況:①感染初期,因結核分枝桿菌感染後需4周以上才能出現超敏反應;②老年人;③嚴重結核患者或正患有其他傳染病,如麻疹導致的細胞免疫低下;④獲得性細胞免疫低下,如愛滋病或腫瘤等用過免疫抑制劑者。為排除假陰性,國內有的單位加用無菌植物血凝素(PHA)針劑 ,0.1ml含10μg作皮試。若24h紅腫大於PHA皮丘者為細胞免疫正常,若無反應或反應不超過PHA皮丘者為免疫低下。
結核菌γ干擾素釋放試驗
細胞免疫介導的結核菌γ干擾素釋放試驗(T-cell interferon gamma release assays,TIGRA,又稱IFNGRA或GRA)是近年來採用酶聯免疫吸附測定(ELISA)或酶聯免疫斑點(ELISPOT)法定量檢出受檢者全血或外周血單個核細胞對結核分枝桿菌特異性抗原的IFN-γ檢測釋放反應,用於結核菌潛伏感染的診斷。IFN-γ為Thl細胞分泌的一種細胞因子,不但能夠反映機體結核的Thl細胞免疫情況,還與體內結核菌的抗原含量密切相關。被結核分枝桿菌抗原致敏的T細胞再遇到同類抗原時能產生高水平的IFN-γ,因此被用於結核潛伏感染的診斷。
目前美國FDA已批准的基於ELISA的QuantiFERON-TB(GIT-G)和歐洲使用的基於ELISPOT的T-Spot.TB,都是以早期分泌性抗原靶-6(ESAT-6)和培養濾液蛋白-10(CFP-10)為抗原的。其中,QFT-G又出現了一種用試管的改良方法,稱為QFT-GIT(QFT-inTube)。ESAT-6和CFP-10都是從短期培養的濾液中分離的低分子量蛋白質,具有良好的免疫原性,而且它們是選自結核分枝桿菌基因組差異區1(region of difference,RD1)基因編碼的結核桿菌特異性蛋白。某些TIGRA試驗除了上述2種抗原外,還常用TB7.7抗原。TB7.7是結核分枝桿菌基因組差異區13(RDl3)基因編碼的結核桿菌特異性抗原。這3種抗原在BCG和絕大部分環境分枝桿菌中都缺失(除外堪薩斯分枝桿菌、海水分枝桿菌和蘇加分枝桿菌),因此避免了與卡介苗和大多數非結核分枝桿菌抗原的交叉反應。
TIGRA的敏感性和特異性都強於TsT,特別是在HIV感染者、自身免疫性疾病、老人和幼兒等免疫力低下人群的檢測中。全球有約1300萬人共同感染了HIV和結核桿菌。感染HIV的LTBI由於免疫缺陷,更容易從潛伏感染髮展為活動性肺結核。Jiang等對BCG計畫接種區域的100個HIV共感染患者用T-Spot.TB檢測,結果顯示T-Spot.TB對於有過BCG接種歷史的HIV共感染的LTBI檢測比TsT更敏感快速,而且特異性高。Balcells等發現,QFT-G比TST在診斷HIV的LTBI時更少受免疫抑制的影響。Stephan等發現,QFT-G和T-Spot.TB在檢測HIV患者的LTBI時比TST更敏感。QFT-G和T-Spot.TB的協同性很差,對於不同CD4細胞數量的患者有不同的結果。Aichelburg等發現,QFTGIT可以用於HIV-1感染者的活動性肺結核檢測。
腫瘤壞死因子α(TNF-α)是一種促炎細胞因子,在多種自身免疫性疾病中起重要的病理作用。但是,抗TNF-α的治療會導致潛伏性肺結核轉變為活動性肺結核,而自身免疫性疾病患者由於免疫抑制。TST容易產生假陰性。研究顯示,QFT-G和T-Spot.TB在免疫介導炎症疾病(IMID)患者中檢測LTBI的敏感性和特異性都比TST高。終末期腎病(ESRD)患者感染結核分枝桿菌的幾率比健康人高10~25.3倍。Lee等比較了QFT-G、T-Spot.TB和TsT在ESRD患者中LTBI的診斷,結果顯示QFT-G和T-Spot.TB的結果較類似,但TsT和QFT-G、T-Spot.TB的實驗結果相差較遠。T-Spot.TB的檢出率比QFT-G高(分別為46.9%和40.0%)。然而,也有研究顯示QFT-G由於有許多不確定性結果,因此不能用於類風濕性關節炎LTBI的檢測。
Bergamini等套用QFT-G、QFT-GIT和T-Spot.TB技術對496個0-19歲的兒童和青少年LTBI進行檢測,結果發現2種QFT檢測得出的結果更相似,QFT相對於T-Spot.TB在4歲以下兒童中得到的非確定性結果更多。Chun等研究顯示,QFT-GIT比TsT在診斷接種過BCG的兒童中LTBI的特異性更強。
上述研究表明,TIGRA在HIV共感染、自身免疫性疾病和免疫力低下的兒童中,對LTBI的檢出率更高。但是,TIGRA存在無法區分活動期和潛伏期結核、需要抽血獲取淋巴細胞、要求專業的操作人員和具備相應條件的實驗室、樣品必須在採集後8h內完成等缺點,現階段仍未能完全取代TsT。另外,現階段研究的樣本都非常小,也沒有診斷LTBI的金標準。因此,對於TIGRA還有待進一步研究。
微生物學檢查法
結核病的症狀和體徵往往不典型,雖可藉助X線攝片診斷,但確診仍有賴於細菌學檢查。
標本
標本的選擇根據感染部位。可取痰、支氣管灌洗液、尿、糞、腦脊液或胸、腹水。其他肺外感染可取血或相應部位分泌液或組織細胞。
直接塗片鏡檢
標本直接塗片或集菌後塗片,用抗酸染色。若找到抗酸陽性菌即可初步診斷。抗酸染色一般用Ziehl-Neelsen法。為加強染色,可用IK(intensified Kinyoun)法染色。將石炭酸復紅染色過夜,用0.5% 鹽酸乙醇脫色30s,則包括大多結核分枝桿菌L型也可著色。為提高鏡檢敏感性,也可用金胺染色,在螢光顯微鏡下結核分枝桿菌呈顯金黃色螢光。
濃縮集菌
先集菌後檢查,可提高檢出率。培養與動物試驗也必須經集菌過程以除去雜菌。腦脊液和胸、腹水無雜菌,可直接離心沉澱集菌。痰、支氣管灌洗液、尿、糞等污染標本需經4% NaOH(痰和鹼的比例為1:4,尿、支氣管灌洗液和鹼的比例為1:1)處理15min,時間過長易使結核分枝桿菌L型與非結核分枝桿菌死亡。尿標本先加5% 鞣酸、5% 乙酸各0.5ml於錐形量筒內靜置,取沉澱物處理。處理後的材料再離心沉澱。取沉澱物作塗片染色鏡檢。若需進一步作培養或動物接種,應先用酸中和後再離心沉澱。
分離培養
將經中和集菌材料接種於固體培養基,器皿口加橡皮塞於37℃培養,每周觀察1次。結核分枝桿菌生長緩慢,一般需2~4周長成肉眼可見的落菌。液體培養可將集菌材料滴加於含血清的培養液,則可於1~2周在管底見有顆粒生長。取沉澱物作塗片,能快速獲得結果,並可進一步作生化、藥敏等測定和區分結核分枝桿菌與非結核分枝桿菌。國內學者已證明結核分枝桿菌L型可存在於血細胞內或粘附於細胞表面。這種患者往往血沉加快,用低滲鹽水溶血後立即接種高滲結核分枝桿菌L型培養基能提高培養陽性率。
動物試驗
將集菌後的材料注射於豚鼠腹股溝皮下,3~4周后若局部淋巴結腫大,結核菌素試驗陽轉,即可進行解剖。觀察肺、肝、淋巴結等器官有無結核病變,並作形態、培養等檢查。若6~8周仍不見發病,也應進行解剖檢查。
快速診斷
一般塗片檢查菌數需5x10 /ml,培養需1x10 /ml,標本中菌數少於此數時不易獲得陽性結果,且培養需時較長。目前已將多聚酶鏈反應(PCR)擴增技術套用於結核分枝桿菌DNA鑑定,每ml中只需含幾個細菌即可獲得陽性,且1-2d得出結果。操作中需注意實驗器材的污染問題,以免出現假陽性。又細菌L型由於缺壁並有代償性細胞膜增厚,而一般常用的溶菌酶不能使細胞膜破裂釋出DNA,以致造成PCR假陰性。用組織磨碎器充分研磨使細胞破裂後,則可出現陽性。目前有條件的單位使用BACTEC法,以含14C棕櫚酸作碳源底物的7H12培養基,測量在細菌代謝過程中所產生的14C量推算出標本中是否有抗酸桿菌,5~7d就可出報告。
近年來國內外研究證明臨床各種類型的肺結核患者中40% 左右分離出L型。經治療的結核病人細菌型消失,L型常持續存在。有空洞患者痰中已不排細菌型者,8% 左右仍可檢出L型。故有學者建議將多次檢出L型亦作為結核病活動判斷標準之一,細菌型與L型 均轉陰才能作為痰陰性。
防治原則
預防
近20年國際組織提出控制結核病主要方法有:①發現和治療痰菌陽性者;②新生兒接種卡介苗。約 80% 獲得保護力。1940年代中國部份城市調查肺結核病死率200/10萬以上。解放後衛生條件改善,1973~1977顯示病死率已下降至30/10萬。但1979年以來全國三次大規模抽樣檢查疫情下降很慢。1979~1990每年患病率遞降率2.8%,痰陽性遞降率為3.0%。目前死亡率19/10萬,仍為其他傳染病之和的2倍。衛生部要求2000年新生兒卡介苗接種率達90%。據統計新生兒時接種過的人以後的發病率比未接種過的減少約80%。
卡介苗是活疫苗,苗內活菌數直接影響免疫效果,故目前已有凍乾疫苗供應。新的核糖體RNA(rRNA)疫苗已引起關注,但尚處在試驗階段。
治療
利福平、異煙肼、乙胺丁醇、鏈黴素為第一線藥物。利福平與異煙肼合用可以減少耐藥性的產生。對嚴重感染,可以吡嗪醯胺與利福平及異煙肼合用。1g乾酪灶或空洞約含結核分枝桿菌106~10。每105~6菌可有1種耐藥突變產生,對2種耐藥需菌1011,故以2藥聯合套用為宜。
![MTB[結核分枝桿菌的縮寫] MTB[結核分枝桿菌的縮寫]](/img/2/022/nBnauM3X4MzM2cTOzADN2EzM1UTM1QDN5MjM5ADMwAjMwUzLwQzL4gzLt92YucmbvRWdo5Cd0FmLzE2LvoDc0RHa.jpg)
